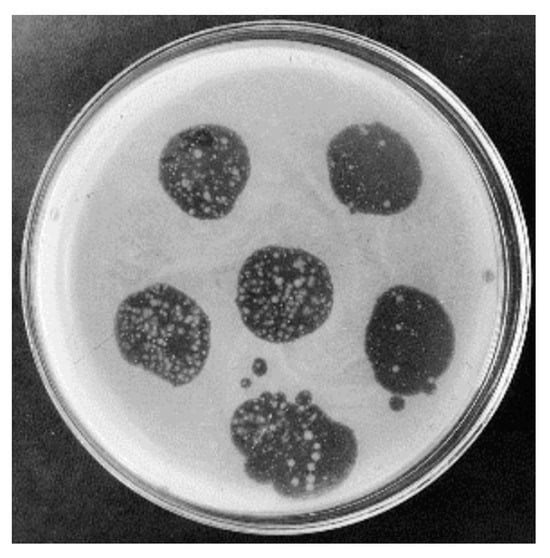
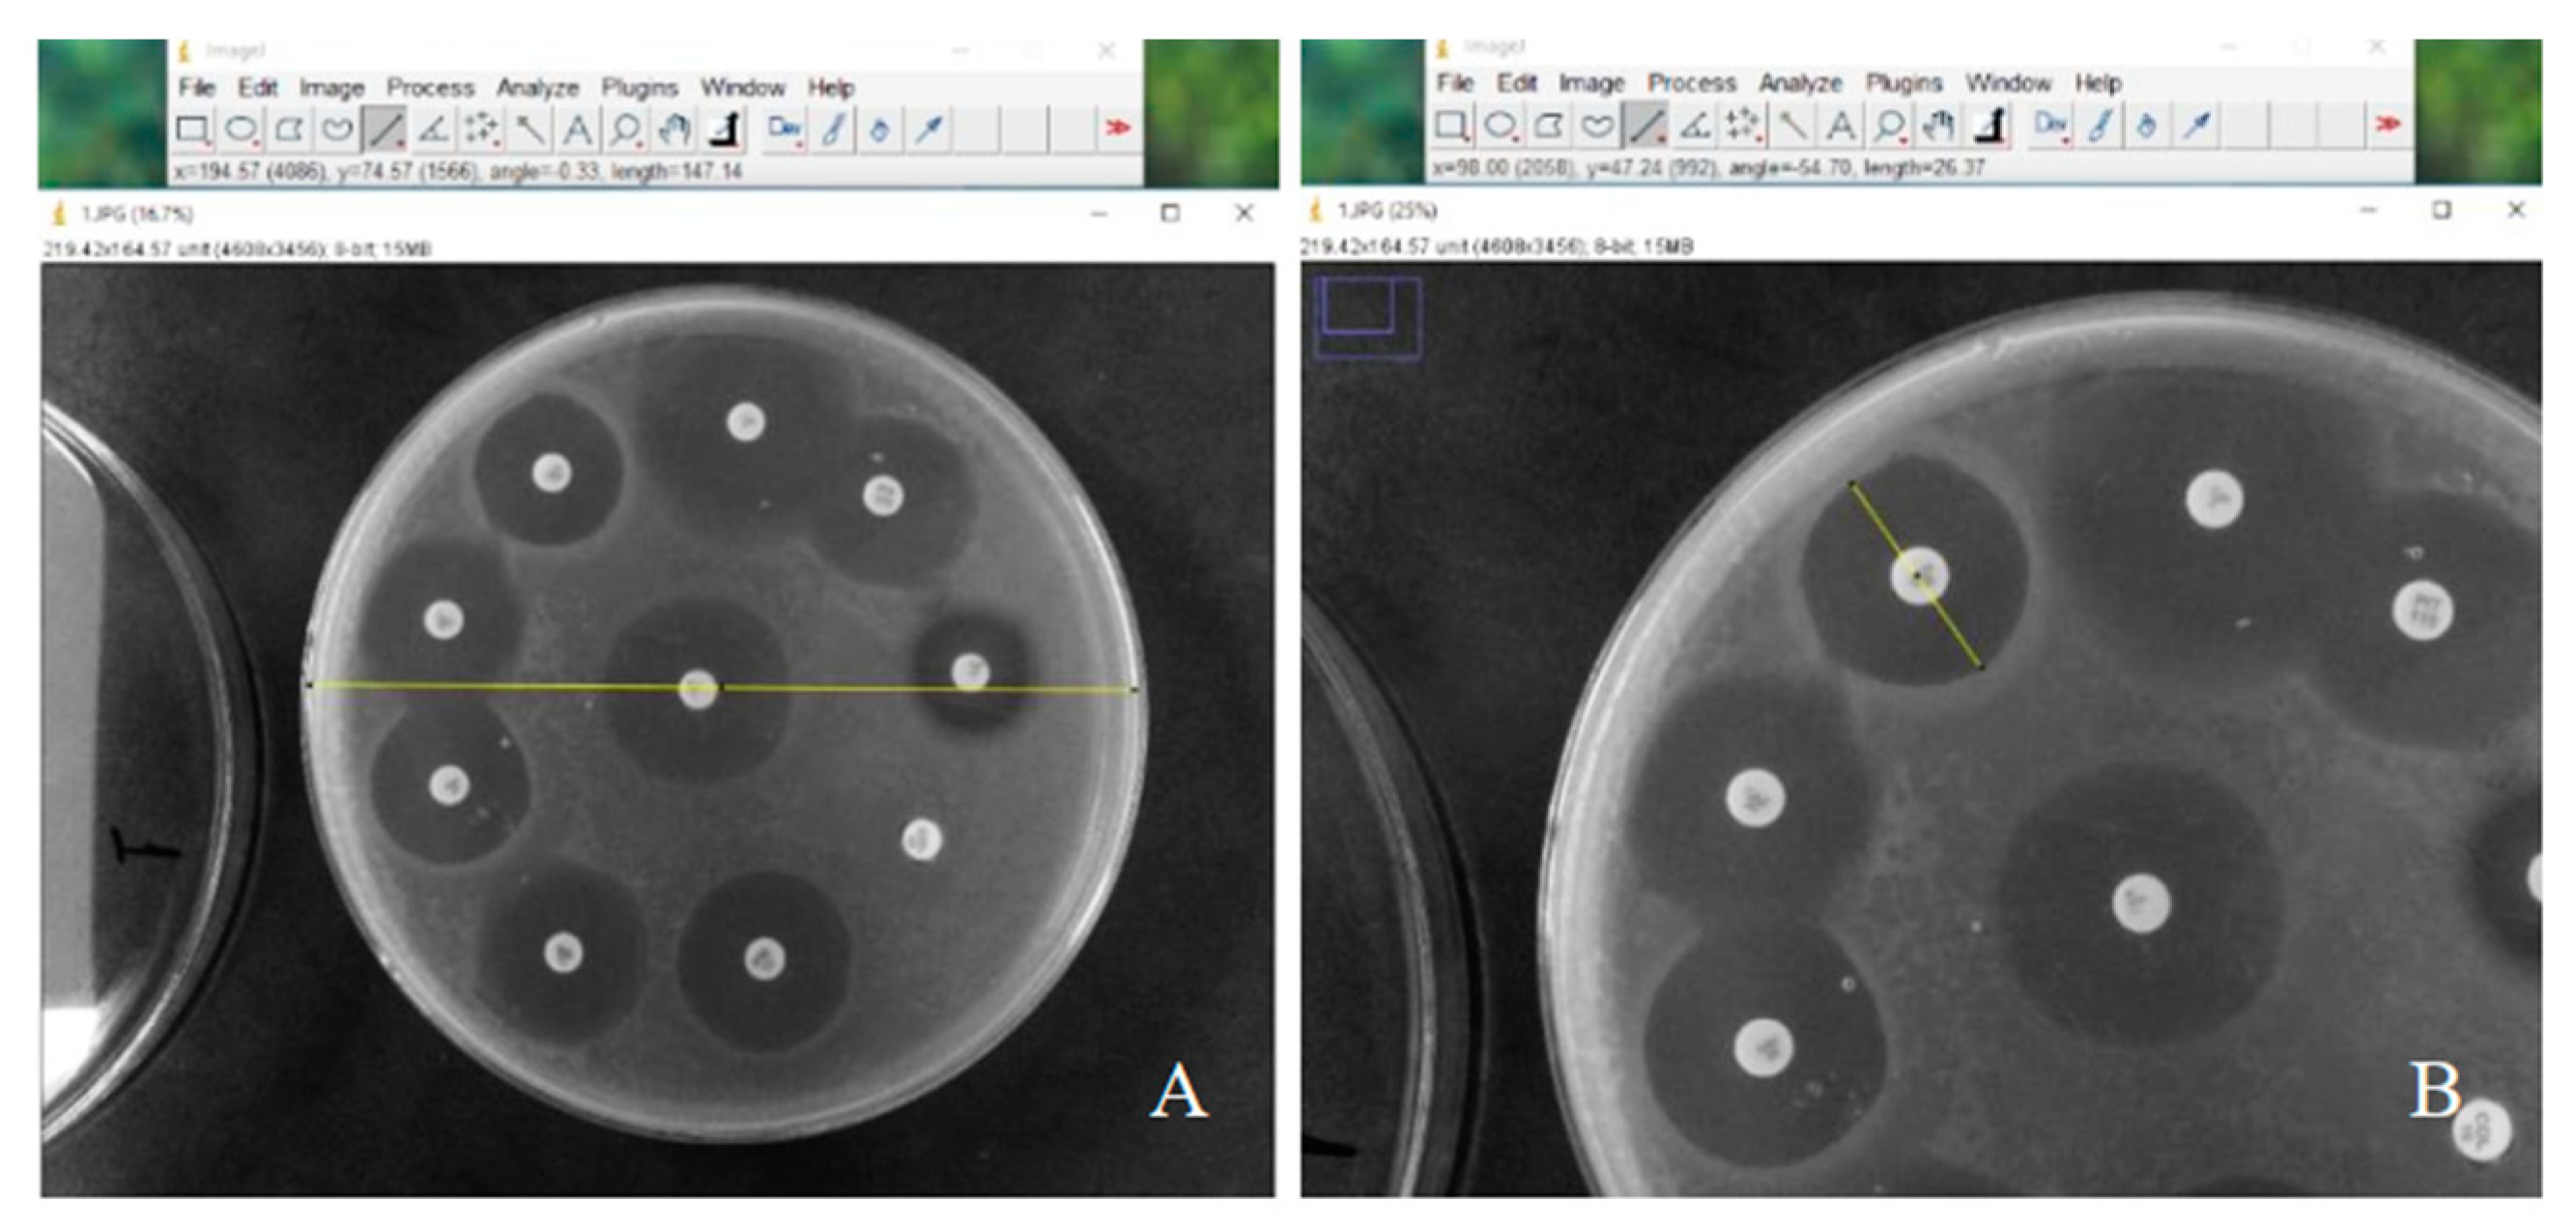
Applbiosci 03 00012 g001

Abstract
The emergence of bacteria resistant to bacteriophage (phage) infection may compromise the success and effectiveness of phage therapy. The aim of this study was to evaluate the in vitro antibacterial activity of five novel phages, as well as the emergence of bacterial resistance to phage infections. The antibacterial activity of lytic phages was evaluated against standard strains of Pseudomonas aeruginosa (ATCC 27853), Escherichia coli (ATCC 25927), Enterococcus faecalis (ATCC 29212) and Staphylococcus aureus (ATCC 6538). Phages were initially grown in the presence of host bacteria in an exponential growth phase, then purified and titrated. In a second exposure, 20 μL of each phage was inoculated with 106 CFU/mL of P. aeruginosa/E. coli/E. faecalis/S. aureus, separately. In a third exposure, resistant colonies were isolated, cultivated and exposed again to the phages. Bacterial colonies resistant to phage infection after the third exposure were evaluated for their susceptibility profile to different antibiotics via the diffusion disk technique. The diameters of the inhibition halos were evaluated with Image J software (version 1.54g) and the definition of the susceptibility profile to antibiotics was determined according to the European Committee on Antimicrobial Susceptibility Testing (EUCAST) criteria. In addition, fourteen cocktails with different phages were formulated to evaluate the emergence of a bacterial resistance to phage infections. The phages exhibited specificity for P. aeruginosa and did not infect E. coli, E. faecalis and S. aureus. The presence of bacterial colonies resistant to phage infection in the three successive exposures was identified, and the bacterial resistance to phage infection was confirmed in all phages titrated at 108 PFU/mL, in four phages titrated at 1010 PFU/mL and in one phage titrated at 1013 PFU/mL. The development of a resistance to infection by phages (~108 PFU/mL) did not change the susceptibility profile of P. aeruginosa to antibiotics and, when evaluating the emergence of a resistance to infection by phage cocktails (~108 PFU/mL, ~1010 PFU/mL, ~1013 PFU/mL), bacterial resistance to phage infection was confirmed in all cocktails with phages titrated at 108 PFU/mL, in ten cocktails with phages titrated at 1010 PFU/mL and in seven cocktails with phages titrated at 1013 PFU/mL. In conclusion, the presence of resistant P. aeruginosa colonies to phage infection after successive exposures was evidenced, although some phages at title ~1010 PFU/mL and ~1013 PFU/mL were effective in inhibiting the growth of resistant colonies. The development of resistance did not change the susceptibility profile of P. aeruginosa to antibiotics. Variants of P. aeruginosa that were resistant to phage infection were isolated and their resistance to infection via the phage cocktail was demonstrated regardless of the viral titer, although some cocktails at title ~1010 PFU/mL and ~1013 PFU/mL were effective in inhibiting the growth of resistant colonies. Despite the emergence of bacterial variants resistant to phage infection, new studies involving the applicability of phages in the control of infections must be conducted.
1. Introduction
The resistance to antimicrobial therapy represents a global warning and challenge for healthcare professionals, as well as those in several other areas, such as water treatment [1], agriculture [2], the food industry [3] and animal husbandry [4]. The progression of diseases and the use of high-cost medications inflates healthcare spending for patients with resistant infections, according to the World Health Organization [5]. Therefore, measures to prevent bacterial resistance, as well as combat resistant microorganisms, have been widely studied, so that the use of bacteriophages (phages) in phage-based therapy or phage therapy demonstrates promising advances in the treatment of infections.
According to a review carried out by Kiani et al. (2021) [6], the use of phages to treat bacterial infections emerged in the mid-1930s, following studies conducted by Félix d’Herelle. From this discovery, several experiments invested in the treatment of bacterial infections through phage therapy; however, with the emergence of antibiotic therapy, studies with phages suffered a decline. The lack of knowledge about the biology and specificity of phages was a point that caused the interruption of the experiments. However, in the last 30 years, phage therapy has been on the rise, due to the critical situation of combating multidrug-resistant microorganisms.
Although phage-based therapy does not replace antibiotics, and guidelines and protocols are needed to standardize their manufacturing because not all phages are suitable for phage therapy, the applicability of this therapy could span the agriculture, aquaculture, dentistry, and veterinary medicine fields [7,8]. So-called temperate phages can transmit, through transduction or transformation, horizontal genes to bacteria, which acquire virulence factors and/or antimicrobial resistance because they integrate the genetic material of the virus (prophage) into their chromosome, and that material is then propagated with each cell division [9]. Lytic phages promote bacterial lysis in the final phase of their cycle, releasing new viral particles capable of infecting nearby bacteria, and the extracellular DNA of the bacteria. This DNA can be acquired by other bacteria through transformation or, through generalized transduction, can be packaged in the phage and transmitted to other bacterial cells. Furthermore, through specialized transduction, the phage DNA and a part of the host bacteria’s DNA can be packaged into the phage capsid, which can infect other bacteria and transmit the genetic material [7].
Despite the controlling bacteria in the planktonic state, phages are also capable of infecting the bacteria in biofilms. Related to dentistry, biofilms can form on teeth, implants, restorations, prostheses, and orthodontic appliances [10]. In the hospital environment, they is capable of being developed into catheters, probes, prostheses and other biomedical devices, posing a risk to immunocompromised patients [11]. In the food industry, biofilms on stainless steel surfaces have been reported and are considered a risk to consumer food safety [12]. In this context, phages with the capacity to infect P. aeruginosa, E. coli, E. faecalis and S. aureus have already been reported [13,14,15] and are relevant for directing further studies on strategies to combat bacterial contamination and/or infections in several areas, such as human health, water treatment [1], agriculture [2], the food industry [3] and animal husbandry [4].
The multidrug resistance of bacteria from the oral cavity and respiratory tract demonstrates the urgency of studies of alternative treatments or treatments combined with antibiotics to control and combat infections [16]. Therefore, strategies to avoid bacterial resistance to antibiotics and phages can be applied, such as the synergistic use of phage therapy with antibiotics, enhancing the action of these drugs and inhibiting the development of a biofilm [17]. Oliveira et al. (2021) demonstrated, in an in vitro study, that a phage cocktail altered the formation of a multidrug-resistant P. aeruginosa biofilm on the surface of endotracheal tubes, which provides possibilities for expanding research into therapeutic combinations as a possible alternative for the treatment of emerging multidrug resistance [18]. Furthermore, the use of phage cocktails rather than isolated phages may limit or prevent the emergence of phage-resistant bacteria and genetic mutations in these strains; however, it may increase the risk of gene transfer and phage-to-phage intrusion [19].
Despite their wide and promising applicability, the emergence of bacteria that are resistant to phages is a recurring factor and can compromise the success and effectiveness of phage therapy. This study aimed to evaluate the in vitro antibacterial activity of five novel phages (vB_PaeM_USP_1, vB_PaeM_USP_2, vB_PaeM_USP_3, vB_PaeM_USP_18 and vB_PaeM_USP_25), as well as the emergence of bacterial resistances to phage infections.
2. Materials and Methods
The antibacterial activity of novel lytic phages (named vB_PaeM_USP_1, vB_PaeM_USP_2, vB_PaeM_USP_3, vB_PaeM_USP_18 and vB_PaeM_USP_25—Oliveira et al., 2020 [20]) was evaluated against standard strains of P. aeruginosa (ATCC 2785 3), E. coli (ATCC 25927), E. faecalis (ATCC 29212) and S. aureus (ATCC 6538). According to the International Committee on the Taxonomy of Viruses, all phages belong to the order Caudovirales and are members of the family Myoviridae [20].
2.1. Expansion, Purification and Titration of Phages
Initially, the phages were multiplied and kept in contact with the host bacterium P. aeruginosa (ATCC—27853) in an exponential growth phase. Purification occurred after the incubation period (Shaker Incubator, Mod. CE-320, CienLab, Campinas, SP, Brazil) at 37 °C for 24 h, under agitation at 120 rpm, and consisted of the addition of a sodium chloride solution (NaCl) at 1 M (1 molar), a transfer to Falcon tubes and a maintenance at 4 °C for 1 h and centrifugation at 4200× g for 20 min, under refrigeration. Five grams (5 g) of 10% (w/v) polyethylene glycol 8.000 (Sigma–Aldrich, St. Louis, MO, USA) was added to the supernatant, manual shaking was performed until complete solubilization, followed by incubation at 4 °C for 19 h. The solution was centrifuged at 4200× g for 20 min at 4 °C. The resulting pellet was resuspended in 10 mL of a dilution buffer and 5 mL of chloroform (Sigma–Aldrich). The tubes were shaken for 30 s and centrifuged at 3000× g for 15 min at 4 °C. The supernatant was collected and filtered through 0.22 μm membranes. The purified phage solutions were stored at 4 °C.
The titration was performed by marking the Petri plate (60 × 15 mm) from 0 to −12, corresponding to the application of the purified phage solutions diluted 100× (10−1 to 10−8). This first exposure of bacteria to the phages was performed in duplicate and, after solidification, the plates were incubated at 37 °C for 24 h. After this period, the presence of lysis plaques was observed through transparent halos equidistant from the dilution without overlapping. Lysis count values were expressed in plaque-forming units per milliliter (PFU/mL) of sample.
2.2. Phage Infection Resistance Assay
After titration, in a second exposure, 20 μL of each phage (~108 PFU/mL, ~1010 PFU/mL and ~1013 PFU/mL) was dropped onto the surface of the semisolid soy tryptone (TS) culture medium (0.8% agar) inoculated with 106 CFU/mL of P. aeruginosa/E. coli/E. faecalis/S. aureus, separately. The plates were incubated at 37 °C for 24 h.
The presence of bacterial colonies of P. aeruginosa resistant to infection by phages in the inner part of the halos was noted. These resistant colonies were isolated, cultivated in a TS broth medium and exposed again to phages, to confirm resistance (third exposure).
2.3. Antibiotic Susceptibility
The area in contact with the phages from the third exposure of P. aeruginosa (~108 PFU/mL) that showed growth was collected and strains resistant to infection were evaluated for their susceptibility to antibiotics, amikacin, cefepime, ceftazidime, ciprofloxacin, gentamicin, imipenem, levofloxacin, meropenem and piperacillin-tazobactam, using the disk diffusion technique. The diameters of the inhibition zones were evaluated using Image J software (version 1.54g) can be seen in Figure 1 and the definition of the antibiotic susceptibility profile was determined according to the European Committee on Antimicrobial Susceptibility Testing (EUCAST) criteria [21].

Figure 1.
Measurement of the diameter of the Petri plate (A) and the inhibition zones of the antibiotic discs using Image J software (B).
2.4. Analysis of the Emergence of Resistance to Phage Cocktail Infection
Based on their genomic similarities, phages were divided into two groups: phages vB_PaeM_USP_1, vB_PaeM_USP_2 and vB_PaeM_USP_3 and phages vB_PaeM_USP_18 and vB_PaeM_USP_25.
Fourteen different cocktails were proposed, combining 100 μL of each select phage, as shown in Table 1, and the ratio of each phage for cocktail composition was 1:1.

Table 1.
Combinations of phages to compose each cocktail.
Aliquots of 20 μL of each cocktail (~108 PFU/mL, ~1010 PFU/mL and ~1013 PFU/mL) were dropped onto each surface of semi-solid (TS) medium (0.8% agar) inoculated with 106 CFU/mL of P. aeruginosa resistant to infection by phages. The plates were incubated at 37 °C for 24 h.
3. Results
3.1. Expansion, Purification and Titration of Phages
After the titration (first exposure), the presence of P. aeruginosa lysis plaques was observed through transparent halos equidistant from the dilution without overlapping, and it was possible to verify the presence of resistant bacteria colonies inside of the halos (Figure 2).

Figure 2.
Phage lysis plates after the titration (first exposure) of P. aeruginosa (~108 PFU/mL), with arrows indicating the growth of resistant bacteria colonies in the transparent halos.
Table 2, below, demonstrates the titer (PFU/mL) of the phages after expansion (~108 PFU/mL).

Table 2.
Phages and their respective P. aeruginosa lysis plaque dilutions to obtain the titer expressed in plaque-forming units per milliliter (PFU/mL).
3.2. Phage Infection Resistance Assay
The phages demonstrated specificity for P. aeruginosa and did not infect E. coli, E. faecalis and S. aureus.
In the second exposure of the phages to P. aeruginosa, the growth of bacteria colonies resistant to infection by the five phages evaluated was observed in the halos of the Petri plates (Figure 3). Colonies of resistant P. aeruginosa bacteria grew with all five phages at a titration of 108 PFU/mL. At a titration of 1010 PFU/mL, only phage vB_PaeM_USP_1 was effective in preventing the growth of resistant colonies. Moreover, at a titration of 1013 PFU/mL, four phages (vB_PaeM_USP_1, vB_PaeM_USP_2, vB_PaeM_USP_3 and vB_PaeM_USP_25) were effective in inhibiting the growth of resistant colonies (Table 3, Table 4 and Table 5).
Figure 3.
Petri plate containing transparent halos with growths of bacterial colonies resistant to phage infection inside, after the second exposure.

Table 3.
Number of resistant P. aeruginosa colonies in each halo of the Petri plate after the second exposure (~108 PFU/mL).

Table 4.
Number of resistant P. aeruginosa colonies in each halo of the Petri plate after the second exposure (~1010 PFU/mL).

Table 5.
Number of resistant P. aeruginosa colonies in each halo of the Petri plate after the second exposure (~1013 PFU/mL).
Subsequently, on the third exposure, the resistant bacterial colonies that were isolated and re-exposed to the phages were largely resistant to viral infection (Figure 4).

Figure 4.
Petri plate showing the growth of bacterial colonies isolated and re-exposed to phages, demonstrating that no plaque lysis was observed after the third exposure.
3.3. Antibiotic Susceptibility
The development of bacterial resistance to infection by phages (~108 PFU/mL) did not change the susceptibility profile of P. aeruginosa to antibiotics, after measuring the diameter of the inhibition halos with Image J software and analyzing the susceptibility profile values according to the European Committee on Antimicrobial Susceptibility Testing (EUCAST) criteria [21]. The antimicrobial susceptibility profiles of Pseudomonas aeruginosa are available in Table 6.

Table 6.
Antimicrobial susceptibility profiles of Pseudomonas aeruginosa in set of third phage exposures.
3.4. Analysis of the Emergence of Resistance to Phage Cocktail Infection
The resistance to infection in P. aeruginosa via phage cocktail (~108 PFU/mL, ~1010 PFU/mL, ~1013 PFU/mL) was confirmed, due to the growth of resistant bacterial colonies in the halos.
Colonies of resistant P. aeruginosa bacteria grew in all cocktails with phages at a titration of 108 PFU/mL. In phage cocktails titrated at 1010 PFU/mL, only cocktails 1, 2, 6 and 10 were effective in preventing the growth of resistant colonies. Finally, in the cocktails with phages titrated at 1013 PFU/mL, only cocktails 2, 9 and 11 were effective in inhibiting the growth of resistant colonies (Table 7, Table 8 and Table 9).

Table 7.
The number of resistant P. aeruginosa colonies in each halo of the Petri plates after infection with a phage cocktail (~108 PFU/mL).

Table 8.
Number of resistant P. aeruginosa colonies in each halo of the Petri plates after infection with a phage cocktail (~1010 PFU/mL).

Table 9.
Number of resistant P. aeruginosa colonies in each halo of the Petri plates after infection with a phage cocktail (~1013 PFU/mL).
4. Discussion
Reducing or eliminating the exposure of microorganisms to patients and healthcare professionals is the objective of infection control; however, the growing bacterial resistance to antimicrobials is a constant concern, because the development of refractory infectious processes, in which there are no longer alternatives for control, are recurrent. Among opportunistic microorganisms, P. aeruginosa can be highlighted, because it is a bacterium with clinical importance due to the difficulty in resolving its infections and therapeutic failures, with it being capable of expressing many virulence factors and admitting resistance to antimicrobials [22].
The specificity of phages for their hosts is relevant, requiring their isolation, identification and characterization for their target strain. The phages (vB_PaeM_USP_1, vB_PaeM_USP_2, vB_PaeM_USP_3, vB_PaeM_USP_18 and vB_PaeM_USP_25) demonstrated specificity for P. aeruginosa and did not infect E. coli, E. faecalis and S. aureus. The individual and specific action of the viruses in this study, however, did not inhibit the development of bacterial resistance to phages. Conversely, phages capable of infecting many hosts (strains of the same species or different genera) are promising, with specificities that vary from narrow to broad, although viral genomic changes are unable to follow the process of the development of bacterial resistance to phages [23].
The failure of phage therapy can be determined by the individual use of phages and, consequently, the emergence of bacterial variants resistant to phages, due to the antiviral mechanisms of bacteria [24]. The scientific literature demonstrates that these mechanisms can be used by bacteria to avoid infections by phages, resulting in the emergence of bacteria that are insensitive to phage infection, through blocking viral adsorption, the presence of restriction endonucleases that degrade the genetic material of the virus, extracellular matrix production, competitive inhibitor production and CRISPR-mediated inhibition [25,26,27].
Vashisth et al. (2023) [28] evaluated the individual and phage cocktails’ lytic actions against a P. aeruginosa biofilm, demonstrating the superior control of bacterial growth by cocktails when compared to the use of phages individually, and it was also reported that cocktails with many phages can promote competitive inhibition. Christiansen et al. (2016) analyzed strains of Flavobacterium psychrophilum (950106-1/1) resistant to different phages and cocktails at different concentrations, which were isolated and characterized, and it was found that initially high viral loads were effective in rapidly reducing the bacteria that were sensitive to phages [29]. Furthermore, a cocktail used in their study provided results like the use of individual phages, although resistant strains were also isolated after exposure to high viral loads, emphasizing the diversity of mutant bacterial populations, in which phages do not have the ability to infect a host.
Yu et al. (2018) [30], after obtaining mutant bacteria resistant to E. coli phages (ATCC 25922), isolated the phage of this variant, and combined it with the lytic phage of the host bacteria, obtaining a cocktail that had higher activity than the isolated phage, acting doubly in response to the emergence of the original host strain and its variant. In the present study, variants of P. aeruginosa that were resistant to infection by the phages evaluated were isolated, re-exposed and were largely resistant to viral infection, and it was found that both phages isolated in the different titrations and the combinations of the fourteen cocktails were not able to prevent the growth of resistant colonies in the halos of the plates, especially at a titration of 108 PFU/mL.
The exclusive use of phages in the treatment of infections may not be a realistic approach, requiring complementary therapies, such as an antibiotic therapy combined with phage therapy [11], to be considered an interesting strategy for controlling infections. This applicability involves the use of subinhibitory doses of antibiotics, capable of increasing the release of phages by bacterial cells, aiming to reduce the doses and/or frequency of antibiotic use and preventing the emergence of antibiotic-resistant bacteria.
The limitations of this study were the use of only a classical microbiological cultivation methodology and bacterial standard strains (P. aeruginosa, E. coli, E. faecalis and S. aureus) to evaluate the antibacterial activity of five novel phages and the emergence of a bacterial resistance to phage infections. Therefore, future studies using molecular methodologies as well as different clinical and/or environmental bacterial strains are important and necessary to answer questions about the mechanisms of bacterial resistance to phage infections.
Thus, the increase in microbial resistance to antimicrobials increasingly limits the arsenal capable of providing successful treatments to patients. This is directly attributed to the development of increasingly frequent and fatal refractory infectious processes. Considering the characteristics and the information described, it is suggested that phage-based therapy is a promising strategy to improve traditionally used antimicrobial therapies.
5. Conclusions
The presence of P. aeruginosa colonies resistant to phage infection after successive exposures was evidenced, although some phages at titles of ~1010 PFU/mL and ~1013 PFU/mL were effective in inhibiting the growth of resistant colonies. The development of resistance did not change the susceptibility profile of P. aeruginosa to antibiotics. Variants of P. aeruginosa that were resistant to phage infection were isolated and their resistance to infection via the phage cocktail was demonstrated, despite some cocktails at titles of ~1010 PFU/mL and ~1013 PFU/mL being effective in inhibiting the growth of resistant colonies. Therefore, bacterial resistance to phage infections is an important and growing topic and new studies involving the applicability of phages in infection control must be conducted.
Author Contributions
Conceptualization, L.d.S.M.-S., V.d.C.O. and E.W.; methodology, L.d.S.M.-S., V.d.C.O. and E.W.; validation, L.d.S.M.-S., V.d.C.O. and E.W.; formal analysis, L.d.S.M.-S., V.d.C.O. and E.W.; investigation, L.d.S.M.-S., V.d.C.O. and E.W.; resources, E.W.; data curation, L.d.S.M.-S., V.d.C.O. and E.W.; writing—original draft preparation, L.d.S.M.-S., V.d.C.O. and E.W.; writing—review and editing, L.d.S.M.-S., V.d.C.O., T.A.d.C., A.C.S.D.d.R. and E.W.; visualization, L.d.S.M.-S., V.d.C.O., T.A.d.C., A.C.S.D.d.R. and E.W.; supervision, E.W.; project administration, L.d.S.M.-S., V.d.C.O. and E.W.; funding acquisition, E.W. All authors have read and agreed to the published version of the manuscript.
Funding
This research was supported by the São Paulo Research Foundation (FAPESP)—funding numbers: 2018/09757-0; 2021/00510-5 and 2022/01992-6, the Pro-Rectory of Research and Innovation at the University of Sao Paulo and the National Council for Scientific and Technological Development (CNPq)—funding numbers: 405622/2018-0; 314787/2021-6 and 443300/2023-2.
Institutional Review Board Statement
Not applicable.
Informed Consent Statement
Not applicable.
Data Availability Statement
Data are contained within the article.
Conflicts of Interest
The authors declare no conflicts of interest.
References
- Shivaram, K.B.; Bhatt, P.; Applegate, B.; Simsek, H. Bacteriophage-based biocontrol technology to enhance the efficiency of wastewater treatment and reduce targeted bacterial biofilms. Sci. Total Environ. 2023, 862, 160723. [Google Scholar] [CrossRef] [PubMed]
- Liu, S.; Quek, S.Y.; Huang, K. Advanced strategies to overcome the challenges of bacteriophage-based antimicrobial treatments in food and agricultural systems. Crit. Rev. Food Sci. Nutr. 2023, 1–25, Advance online publication. [Google Scholar] [CrossRef] [PubMed]
- Ge, H.; Fu, S.; Guo, H.; Hu, M.; Xu, Z.; Zhou, X.; Chen, X.; Jiao, X. Application and challenge of bacteriophage in the food protection. Int. J. Food Microbiol. 2022, 380, 109872. [Google Scholar] [CrossRef] [PubMed]
- Clavijo, V.; Baquero, D.; Hernandez, S.; Farfan, J.C.; Arias, J.; Arévalo, A.; Donado-Godoy, P.; Vives-Flores, M. Phage cocktail SalmoFREE® reduces Salmonella on a commercial broiler farm. Poult. Sci. 2019, 98, 5054–5063. [Google Scholar] [CrossRef] [PubMed]
- World Health Organization. Health and economic impacts of antimicrobial resistance in the Western Pacific Region, 2020–2030. 2023. Available online: https://www.who.int/publications/i/item/9789290620112 (accessed on 23 November 2023).
- Kiani, A.K.; Anpilogov, K.; Dhuli, K.; Paolacci, S.; Benedetti, S.; Manara, E.; Guerri, G.; Dautaj, A.; Beccari, T.; Dundar, M.; et al. Naturally-occurring and cultured bacteriophages in human therapy. Eur. Rev. Med. Pharmacol. Sci. 2021, 25 (Suppl. 1), 101–107. [Google Scholar] [CrossRef] [PubMed]
- Shanmugasundaram, S.; Nayak, N.; Puzhankara, L.; Kedlaya, M.N.; Rajagopal, A.; Karmakar, S. Bacteriophages: The dawn of a new era in periodontal microbiology? Crit. Rev. Microbiol. 2024, 50, 212–223. [Google Scholar] [CrossRef]
- Strathdee, S.A.; Hatfull, G.F.; Mutalik, V.K.; Schooley, R.T. Phage therapy: From biological mechanisms to future directions. Cell 2023, 186, 17–31. [Google Scholar] [CrossRef]
- Gummalla, V.S.; Zhang, Y.; Liao, Y.T.; Wu, V.C.H. The Role of Temperate Phages in Bacterial Pathogenicity. Microorganisms 2023, 11, 541. [Google Scholar] [CrossRef]
- Parolo, C.C.F.; Arthur, R.A. Chapter 5.2: Oral Microbial Biofilms. Monogr. Oral Sci. 2023, 31, 62–77. [Google Scholar] [CrossRef]
- Stevenson, P.; Marguet, M.; Regulski, M. Biofilm and Hospital-Acquired Infections in Older Adults. Crit. Care Nurs. Clin. N. Am. 2023, 35, 375–391. [Google Scholar] [CrossRef]
- Azari, R.; Yousefi, M.H.; Fallah, A.A.; Alimohammadi, A.; Nikjoo, N.; Wagemans, J.; Berizi, E.; Hosseinzadeh, S.; Ghasemi, M.; Mousavi Khaneghah, A. Controlling of foodborne pathogen biofilms on stainless steel by bacteriophages: A systematic review and meta-analysis. Biofilm 2023, 7, 100170. [Google Scholar] [CrossRef]
- Padmesh, S.; Singh, A.; Chopra, S.; Sen, M.; Habib, S.; Shrivastava, D.; Johri, P. Isolation and characterization of novel lytic bacteriophages that infect multi drug resistant clinical strains of Escherichia coli. Environ. Sci. Pollut. Res. Int. 2023. Advance online publication. [Google Scholar] [CrossRef]
- Kebriaei, R.; Lehman, S.M.; Shah, R.M.; Stamper, K.C.; Kunz Coyne, A.J.; Holger, D.; El Ghali, A.; Rybak, M.J. Optimization of Phage-Antibiotic Combinations against Staphylococcus aureus Biofilms. Microbiol. Spectr. 2023, 11, e0491822. [Google Scholar] [CrossRef]
- Moryl, M.; Różalski, A.; de Figueiredo, J.A.P.; Palatyńska-Ulatowska, A. How Do Phages Disrupt the Structure of Enterococcus faecalis Biofilm? Int. J. Mol. Sci. 2023, 24, 17260. [Google Scholar] [CrossRef]
- Moda-Silva, L.S.; Oliveira, V.C.; Silva-Lovato, C.H.; Fernández-Barat, L.; Watanabe, E. Phage-based therapy: Promising applicability in the control of oral dysbiosis and respiratory infections. Future Microbiol. 2022, 17, 1349–1352. [Google Scholar] [CrossRef]
- Vera-Mansilla, J.; Silva-Valenzuela, C.A.; Sánchez, P.; Molina-Quiroz, R.C. Bacteriophages potentiate the effect of antibiotics by eradication of persister cells and killing of biofilm-forming cells. Res. Microbiol. 2023, 174, 104083. [Google Scholar] [CrossRef]
- Oliveira, V.C.; Macedo, A.P.; Melo, L.D.R.; Santos, S.B.; Hermann, P.R.S.; Silva-Lovato, C.H.; Paranhos, H.F.O.; Andrade, D.; Watanabe, E. Bacteriophage Cocktail-Mediated Inhibition of Pseudomonas aeruginosa Biofilm on Endotracheal Tube Surface. Antibiotics 2021, 10, 78. [Google Scholar] [CrossRef]
- Liu, S.; Lu, H.; Zhang, S.; Shi, Y.; Chen, Q. Phages against Pathogenic Bacterial Biofilms and Biofilm-Based Infections: A Review. Pharmaceutics 2022, 14, 427. [Google Scholar] [CrossRef]
- Oliveira, V.C.; Bim, F.L.; Monteiro, R.M.; Macedo, A.P.; Santos, E.S.; Silva-Lovato, C.H.; Paranhos, H.F.O.; Melo, L.D.R.; Santos, S.B.; Watanabe, E. Identification and Characterization of New Bacteriophages to Control Multidrug-Resistant Pseudomonas aeruginosa Biofilm on Endotracheal Tubes. Front. Microbiol. 2020, 11, 580779. [Google Scholar] [CrossRef]
- European Committee on Antimicrobial Susceptibility Testing (EUCAST). Reading Guide—EUCAST Disk Diffusion Method for Antimicrobial Susceptibility Testing, v. 10.0, 2023. Available online: https://www.eucast.org/ast_of_bacteria/disk_diffusion_methodology (accessed on 3 September 2023).
- Tortora, G.J.; Funke, B.R.; Case, C.L. Microbiologia, 12th ed.; Artmed: Porto Alegre, Brazil, 2017. [Google Scholar]
- De Jonge, P.A.; Nobrega, F.L.; Brouns, S.J.J.; Dutilh, B.E. Molecular and Evolutionary Determinants of Bacteriophage Host Range. Trends Microbiol. 2019, 27, 51–63. Available online: https://www.cell.com/trends/microbiology/fulltext/S0966-842X(18)30178-1?_returnURL=https%3A%2F%2Flinkinghub.elsevier.com%2Fretrieve%2Fpii%2FS0966842X18301781%3Fshowall%3Dtrue (accessed on 9 February 2023). [CrossRef]
- Teklemariam, A.D.; Al-Hindi, R.R.; Qadri, I.; Alharbi, M.G.; Ramadan, W.S.; Ayubu, J.; Al-Hejin, A.M.; Hakim, R.F.; Hakim, F.F.; Hakim, R.F.; et al. The Battle between Bacteria and Bacteriophages: A Conundrum to Their Immune System. Antibiotics 2023, 12, 381. [Google Scholar] [CrossRef] [PubMed]
- Seed, K.D. Battling Phages: How Bacteria Defend against Viral Attack. PLoS Pathog. 2015, 11, e1004847. [Google Scholar] [CrossRef] [PubMed]
- León, L.M.; Park, A.E.; Borges, A.L.; Zhang, J.Y.; Bondy-Denomy, J. Mobile element warfare via CRISPR and anti-CRISPR in Pseudomonas aeruginosa. Nucleic Acids Res. 2021, 49, 2114–2125. Available online: https://www.ncbi.nlm.nih.gov/pmc/articles/PMC7913775/ (accessed on 9 April 2023). [CrossRef] [PubMed]
- Yadalam, P.K.; Arumuganainar, D.; Anegundi, R.V.; Shrivastava, D.; Alftaikhah, S.A.A.; Almutairi, H.A.; Alobaida, M.A.; Alkaberi, A.A.; Srivastava, K.C. CRISPR-Cas-Based Adaptive Immunity Mediates Phage Resistance in Periodontal Red Complex Pathogens. Microorganisms 2023, 11, 2060. [Google Scholar] [CrossRef] [PubMed]
- Vashisth, M.; Jaglan, A.B.; Yashveer, S.; Sharma, P.; Bardajatya, P.; Virmani, N.; Bera, B.C.; Vaid, R.K.; Anand, T. Development and Evaluation of Bacteriophage Cocktail to Eradicate Biofilms Formed by an Extensively Drug-Resistant (XDR) Pseudomonas aeruginosa. Viruses 2023, 15, 427. Available online: https://www.mdpi.com/1999-4915/15/2/427 (accessed on 15 June 2023).
- Christiansen, R.H.; Madsen, L.; Dalsgaard, I.; Castillo, D.; Kalatzis, P.G.; Middelboe, M. Effect of Bacteriophages on the Growth of Flavobacterium psychrophilum and Development of Phage-Resistant Strains. Microb. Ecol. 2016, 71, 845–859. [Google Scholar] [CrossRef]
- Yu, L.; Wang, S.; Guo, Z.; Liu, H.; Sun, D.; Yan, G.; Hu, D.; Du, C.; Feng, X.; Han, W.; et al. A guard-killer phage cocktail effectively lyses the host and inhibits the development of phage-resistant strains of Escherichia coli. Appl. Microbiol. Biotechnol. 2018, 102, 971–983. [Google Scholar] [CrossRef]
Disclaimer/Publisher’s Note: The statements, opinions and data contained in all publications are solely those of the individual author(s) and contributor(s) and not of MDPI and/or the editor(s). MDPI and/or the editor(s) disclaim responsibility for any injury to people or property resulting from any ideas, methods, instructions or products referred to in the content. |
© 2024 by the authors. Licensee MDPI, Basel, Switzerland. This article is an open access article distributed under the terms and conditions of the Creative Commons Attribution (CC BY) license (https://creativecommons.org/licenses/by/4.0/).